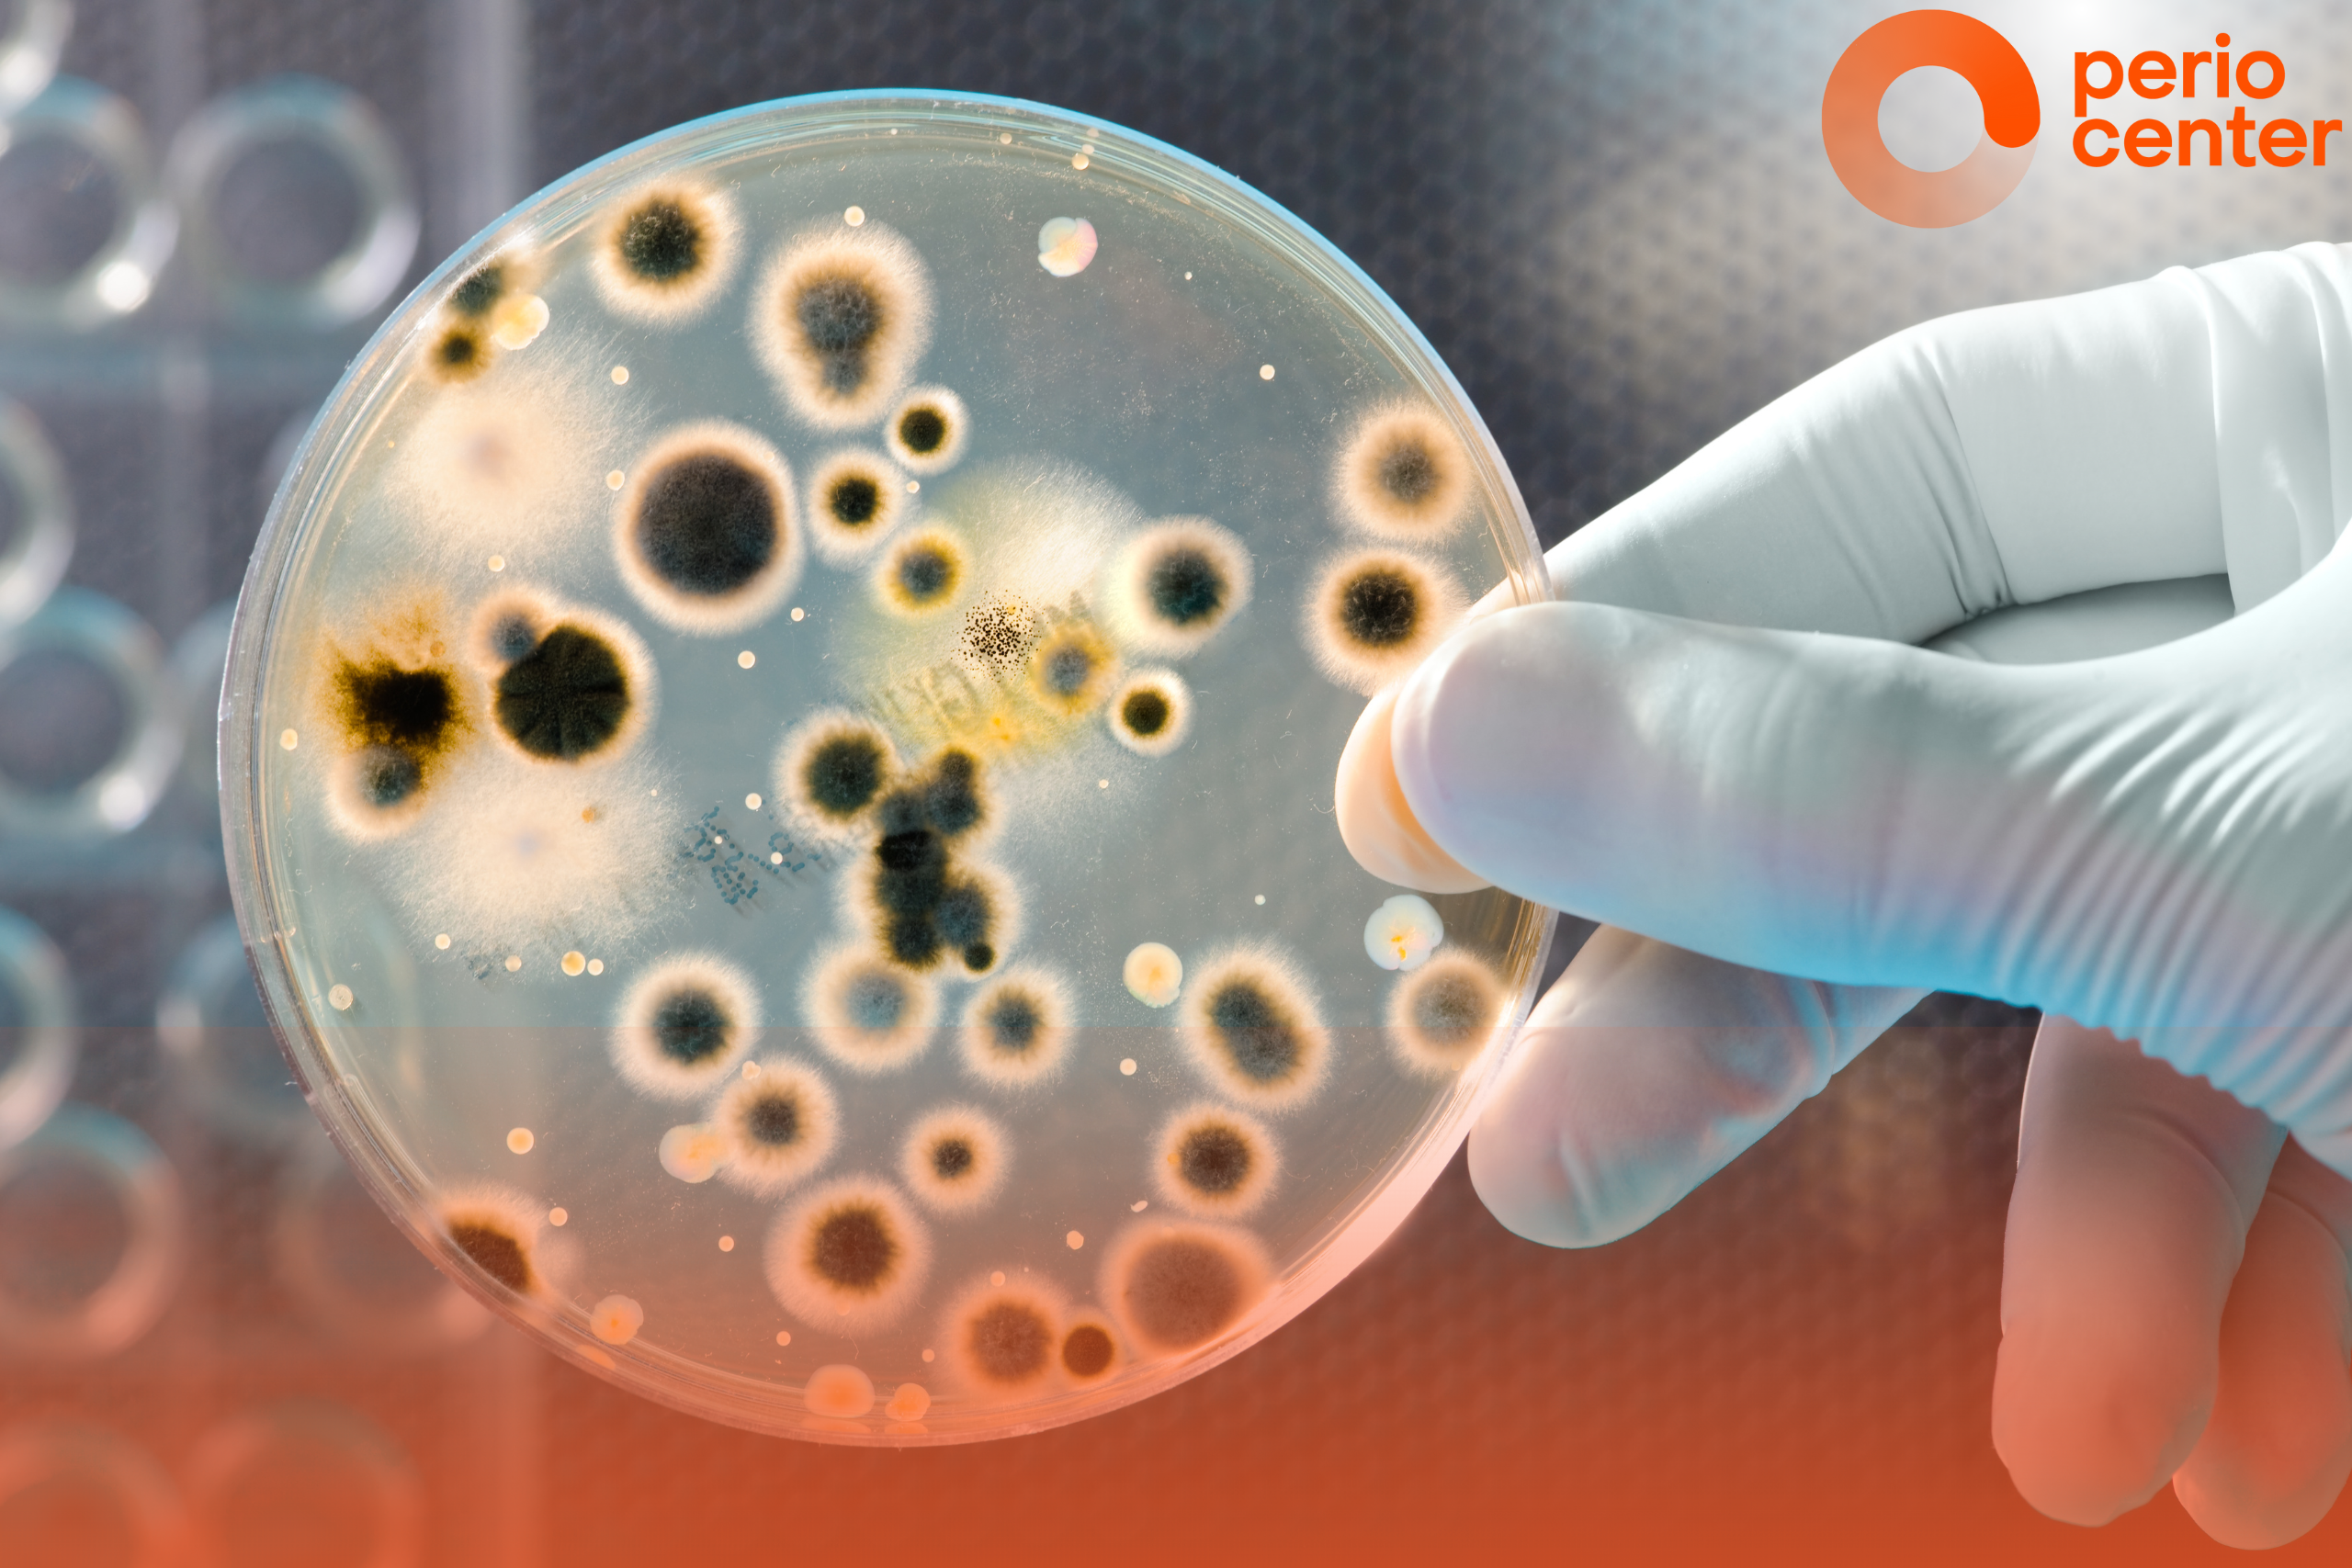

Мікробіом ротової порожнини: чому не всі бактерії — вороги?
У нашій уяві бактерії часто асоціюються з чимось шкідливим. Проте в реальності все не так однозначно. У ротовій порожнині мешкає понад 700 видів бактерій — і більшість із них виконують важливі функції, допомагаючи нам підтримувати здоров’я ясен і зубів.
Що таке мікробіом рота?
Мікробіом ротової порожнини — це складна екосистема мікроорганізмів: бактерій, грибів і вірусів, які живуть на слизових оболонках, язику, яснах, зубах та навіть на пломбах і брекетах. У здорової людини мікробіом перебуває в балансі: “хороші” бактерії стримують ріст “поганих”, запобігаючи запаленням та інфекціям.
Навіщо нам “хороші” бактерії?
Ці мікроорганізми:
- беруть участь у первинному розщепленні їжі,
- підтримують природний рівень кислотності в роті,
- захищають від агресивних зовнішніх мікробів,
- тренують імунну систему.
Коли цей баланс порушується — наприклад, через погану гігієну, стрес, неправильне харчування або антибіотики — зростає ризик розвитку захворювань, зокрема гінгівіту та пародонтиту.
Бактерії, які викликають пародонтит
Пародонтит — це хронічне захворювання ясен, яке поступово руйнує тканини, що утримують зуби. Основними його “винуватцями” є анаеробні (ті, що живуть без кисню) бактерії, такі як:
- Porphyromonas gingivalis
- Tannerella forsythia
- Treponema denticola
Ці бактерії можуть ховатися в пародонтальних кишенях — мікропросторах між яснами і зубом, де їм дуже комфортно, особливо якщо гігієна порожнини рота неідеальна. Вони провокують запалення, викликають кровоточивість ясен, неприємний запах із рота та, у запущених випадках, втрату зубів.
Як зберегти баланс?
Поради від PERIO CENTER:
- Чистіть зуби двічі на день м’якою щіткою та користуйтеся міжзубними йоржиками або зубною ниткою;
- Не забувайте про очищення язика (існують спеціальні скребки для його чищення);
- Раз на пів року проходьте професійну гігієну;
- Вживайте менше цукру — він живить “погані” бактерії;
- Не використовуйте антибіотики без призначення лікаря, це шкодить всьому організму;
- Звертайтеся до пародонтолога при перших ознаках запалення.
Мікробіом рота — це не ворог, а наш партнер. Збалансована мікрофлора — основа здоров’я ясен і зубів. Завдання сучасної стоматології — не тільки боротися з “поганими” бактеріями, а й допомагати зберігати природний баланс.
Турбуйтесь про своє здоров’я, а ми попіклуємось про Ваші ясна🧡
Якщо Ви помітили будь-які ознаки запалення або кровоточивість – звертайтесь до пародонтологів PERIO CENTER – ми вам допоможемо!
